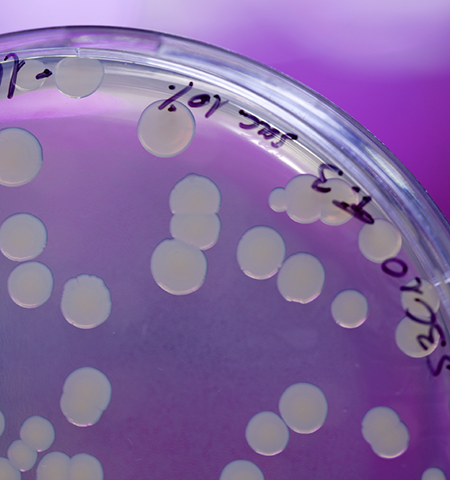

"Un buen nivel de cadena de frío se traduce en un uso eficiente de los recursos"
Una regla que aún no se interioriza en la industria moderna de la fruta fresca es que cuánto más rápido se enfría el producto, mejor aspecto tendrá cuando llegue a manos del consumidor. El especialista en postcosecha y cadena de frío, Dr. Luis Luchsinger sostiene que, como consecuencia de los problemas surgidos con la deshidratación y pardeamiento del raquis de las nuevas variedades de uva de mesa, recién se ha comenzado a tomar nota de la importancia de esta regla. Al respecto, da detalles de una innovación que ha lanzado a nivel de diseño de túneles de pre-frío de gran potencia para la industria frutícola.
Marienella Ortiz

El Dr. Luis Luchsinger recuerda que su cariño por la fruta y sus cuidados nació en el campo, de la mano de su padre, que era fruticultor. Si bien esto lo encaminó a seguir la carrera de agronomía en la Universidad de Chile, allí se encontró con su segundo mentor, el Dr. Antonio Lizana, conocido como el ‘padre de la postcosecha’ en América Latina, quien le sirvió de inspiración para dedicar los últimos 25 años de su vida profesional al trabajo de afinar y encontrar la mejor administración de la cadena frío, como una garantía del arribo de una fruta fresca que satisfaga al consumidor.
“En uno de los últimos años de la carrera tomé una asignatura que se llamaba manejo postcosecha de fruta a cargo del Dr. Antonio Lizana. Él fue el que empezó todo esto, tras estudiar en la Universidad de California, Davis, y empezó a enseñar esta especialidad cuando no se sabía qué era la postcosecha. Él no estaba haciendo el ramo propiamente, porque como era decano tenía poco tiempo, pero me hizo solamente dos clases y quedé impresionado. Me dio toda una visión global de lo que significaba para Chile poder llegar con la fruta a cualquier lugar del mundo”, recuerda.
Cuando empezó a trabajar en postcosecha a inicios de los años noventa, el Dr. Luchsinger comenta que le costó un poco determinar cuál era el principal problema detrás del manejo de la fruta, luego de cosechada. “Cuando regresé de hacer mi postgrado en EE UU empecé a trabajar en una empresa en Copiapó, como asesor, donde un amigo era el gerente general. Recuerdo que la primera vez que le pregunté, cuando terminó la temporada, qué tal le había parecido la asesoría – estamos hablando de un amigo- me dijo ‘mmm, sí, bien, bien’. Claro, no me dijo que estaba mal, pero me dio a entender que no era lo que esperaba”, relata.
Tras hacer un repaso de todos los pasos de rigor que había cumplido en el manejo postcosecha de la fruta (la cosecha, el estado de madurez, etc.) se dio cuenta que había algo que estaba quedado fuera de la ecuación, y era el enfriamiento de la fruta. En ese entonces, los ingenieros de refrigeración eran los únicos encargados de la cadena de frío. Allí empezó a meterse en este campo y reconoce que en un inicio no entendía nada. Sin embargo, también descubrió que los ingenieros a cargo tampoco entendían mucho. “Había un tremendo vacío en el tema de la cadena de frío”, recalca.
Luego de mucha persistencia y pruebas continuas sobre los sistemas de enfriamiento, descubrió que en postcosecha lo importante es primero la temperatura, segundo la temperatura, tercero la temperatura, cuarto la temperatura, quinto la temperatura, sexto la temperatura y después todo lo demás: la humedad relativa, la concentración de gas, el control de hongos, el etileno… Pese a que esto es constatado por la ciencia, resalta que en la actualidad el manejo postcosecha y la cadena de frío se sigue haciendo muy mal.
– ¿Cómo ha evolucionado todo el manejo del frío en estos 25 años?
– Ha evolucionado muy lento. En general, seguimos dejando toda la cadena de frío a la industria de la refrigeración. En mi esquema mental – algo que desarrollé en el año 2000-, veo la cadena de frío con tres aspectos fundamentales, que representan el triángulo del enfriamiento. Un aspecto está relacionado a cómo enfriar la fruta, porque trabajamos con una fruta fresca que está viva. Luego, tenemos el diseño en sí de los equipos relacionados a la industria de la refrigeración, que ve la parte de motores, máquinas, compresores, condensadores, refrigerantes. Allí están los ingenieros que, muchas veces, no entienden nada de fruta. En el tercer aspecto, tienes los envases y embalajes y todo lo que está al interior de la caja. Al centro de este triángulo está el consumidor y, sin él, no tenemos trabajo. Entonces, tienes a la gente que enfría, generalmente, que no sabe de fruta, no sabe de envases y embalajes y muchas veces no sabe de sistemas de enfriamiento, de la parte mecánica. Algo similar pasa con el que hace las máquinas y con el proveedor de envases y embalajes. Entonces, al final, cada uno está trabajando por separado. Uno habla inglés, otro ruso y el de allá chino mandarín. No hay comunicación, no hay una integración. (Ver esquema de ‘triángulo de enfriamiento’).

– ¿No hay quién integre estos tres aspectos?
– He logrado integrar todo esto. La postcosecha es un paraguas grande, donde más abajo está el frío. A mí me dicen que soy especialista en frío, cuando en realidad soy especialista en postcosecha y en cadena de frío. No hay especialistas en cadena de frío. ¿Cómo sé que no los hay? En este aprendizaje de veintitantos años, he buscado, desesperadamente, lugares dónde aprender. Tomé casi todo tipo de curso y la mayoría de estos era de refrigeración (motor y máquina), pero no de la administración del frío. Por lo tanto, sé perfectamente lo que te estoy diciendo.
Es un aprendizaje que lo hemos tenido que hacer en la región, porque en países de otros continentes no dependen tanto de la cadena de frío. Sin embargo, también comentabas que es un aprendizaje que camina lento y no termina de cuajar. ¿A qué se debe?
– En Chile, por ejemplo, existe mucho recambio de jefes, de operarios. Cuando empecé en Perú no pasaba eso, pero ahora también es normal encontrar que la gente se cambia, como se cambia de ropa. Hoy en día es muy normal porque es parte de la oferta y demanda, así funciona esto.
EL PERÚ INNOVÓ EN EL MANEJO DEL FRÍO
Cuando empezó a asesorar a empresas en el Perú, comenta que el manejo del frío era bastante precario, aunque no mucho más que en Chile. Sin embargo, destaca que trabajar en Perú significó contar con dos grandes ventajas, desde el punto de vista de un asesor, que fue el tamaño de las operaciones de las empresas y la permeabilidad a tomar en cuenta las recomendaciones.

– ¿Qué significó en la práctica estas dos ventajas?
– En el caso de la primera ventaja, como son empresas muy grandes, las decisiones se toman muy rápido. Hay un comité directivo, un director, un equipo técnico o el dueño que toma las decisiones. Entonces, convences a 2 o 3 personas y se hace. En cambio, en Chile, todos creen que saben, debido a que ha sido el principal país exportador de fruta del mundo. Si uno no sabe manejar el éxito, te entra la soberbia y te estancas. Entonces, es impresionante como Chile se ha ido quedando en ese sentido, mientras que Perú ha ido subiendo y ahora es el segundo exportador de uva y el primer exportador de arándanos frescos del mundo. La siguiente ventaja es que en Perú estaban más abiertos al conocimiento, confiaban mucho en los especialistas chilenos.
– ¿Te refieres a que tu conocimiento se toma en cuenta?
– Se toma en cuenta. En cambio, en Chile, es al revés. A mí me cuesta mucho trabajar en Chile, porque permanentemente uno tiene que estar convenciendo al otro de que el especialista es uno. Por eso es que me calza la frase ‘nadie es profeta en su propia tierra’. Ahora, hay un problema grave que tiene Perú, y es que por inseguridad, los jefes no enseñan para abajo. Mejor dicho, no hay transmisión de enseñanza para abajo. Hay mucho de ‘haz esto’, pero el por qué no lo hay. En cambio, en Chile existe la cultura de que si tú eres jefe, mientras mejor prepares al que está más abajo, tú puedes dedicarte a hacer otras cosas.
– Justamente me indicabas que falta una integración del conocimiento y esto que mencionas lo agrava.
– En efecto, en Perú son muy cerrados con la información. De hecho, no se permite que técnicos o profesionales de una empresa compartan información o se junten con gente de otras empresas. Son muy celosos; en cambio, en Chile, en ese sentido, es muy abierto. Si yo tengo un problema técnico, sabemos que mientras más lo comente a mis colegas de distintas empresas, habrá una solución. Nos visitamos entre empresas, porque está bien visto que hables con colegas y técnicos de otras compañías. En Perú no se da eso.
– Pese a esto, comentabas que el Perú avanzó rápido en el conocimiento del manejo de frío
– El nivel peruano en cadena de frío es muy superior al chileno, hoy en día. Muy pero muy superior. Un buen nivel de cadena de frío se traduce en un uso eficiente de los recursos. Claro, también tienes que pensar que eso es por un motivo y es porque tienen mosca de la fruta. Y, al tener mosca de la fruta, tienes ‘cold treatment’, es decir, una mayor exigencia con el frío. Senasa no te va a permitir embarcar una fruta que no cumple con los requisitos de temperatura. Yo te puedo asegurar que sin la mosca de la fruta seguirían manejando el frio igual como lo hacemos en Chile.
– ¿Cómo se tradujo eso en una mejor cadena de frio?
– En Perú asesoré a la primera empresa en el mundo que enfrió la materia prima, Complejo Agroindustrial Beta; específicamente, la uva de mesa. Eso lo hicimos aproximadamente en 2013 o 2014. Ya después siguieron otras y hoy en día son como siete que lo hacen así.
– En Chile no era necesario enfriar la materia prima.
– Recién desde el año pasado lo hacemos.
– ¿Por qué más tarde que en Perú?
– No se hacía porque no se hacía, simplemente. Lo que hizo reventar el sistema e hizo reflexionar al sector sobre la necesidad de enfriar la materia prima fue cuando aparecieron las nuevas variedades, que tienen un raquis muy débil. Con la forma habitual como trabajamos la uva de mesa, las variedades tradicionales aguantaban y llegaban con un raquis de un verde bastante decente a su destino, pero eso mismo no ocurre en la mayoría de las variedades nuevas.
ENFRIAR RÁPIDO LA FRUTA

Según comenta el Dr. Luis Luchsinger, la gran mayoría de productores y exportadores de fruta cree que si se enfría rápido la fruta se deshidratará y estropeará. Sin embargo, eso es un mito, afirma. Por ese motivo, muchos de los sistemas de enfriamiento tradicionales no toman en cuenta la necesidad de enfriar lo más rápido posible la fruta. Además, apunta que ser ineficiente o hacer sistemas de enfriamiento lentos, al final, encarecerá la operación. En tanto, hacer un sistema de enfriamiento más veloz saldrá más barato que uno tradicional.
Al respecto, el especialista subraya que en 2020 finalizó el diseño de nuevos túneles de pre-frío que, según apunta, “son los más potentes en el mundo”. Estos ya fueron instalados en dos empresas chilenas con excelentes resultados en la calidad de la uva de mesa en destino. Por esta razón, ha recibido solicitudes de empresarios peruanos que también evalúan contar con estos nuevos túneles. Sin embargo, debido a la pandemia, no ha podido viajar a Perú desde hace 18 meses y se ha visto imposibilitado de trabajar directamente este tema con la industria local.
– ¿En qué consiste este nuevo diseño de túneles de pre-frio?
– Se trata de túneles extremadamente potentes, que enfrían muy rápido la fruta, disminuyendo la deshidratación (pérdida de peso) a un menor costo y con un menor consumo energético que los sistemas tradicionales. Si enfrío más rápido la fruta, voy a requerir un poco menos de potencia eléctrica y, al final, el conjunto del proyecto del túnel sale más barato.
– ¿Con este enfriamiento más rápido, entonces, se evitan problemas de raquis de estas nuevas variedades de uva de mesa?
– Exactamente. Mi objetivo es el consumidor, como me lo hizo ver mi mentor, el Dr. Antonio Lizana. Si tú no tienes un consumidor que esté satisfecho, que disfrute de la experiencia de comerse la fruta, vas a perder el negocio.
– Ya hubo envíos al extranjero con la fruta enfriada en estos túneles. ¿Cuál ha sido el resultado?
– Ha sido un éxito y muchas empresas peruanas me han llamado y me dicen ‘tengo problemas con el raquis de las nuevas variedades. ¿Ahora qué hago?’ Entonces, les contesto que tienen que hacer lo mismo que les vengo diciendo desde hace cinco años, enfriar la fruta rápidamente.
– ¿La inversión de estos túneles se justifica para el proceso de enfriamiento?
– Absolutamente. Con una empresa en Perú hicimos el cálculo y la inversión se paga en el primer año, porque llegas con un raquis verde –obviamente, has tenido que partir de una buena materia prima- de uva de mesa que, para los seres humanos, es sinónimo de frescura. Instintivamente, si los consumidores ven dos racimos, donde uno está con el raquis verde y el otro está marrón, se irán automáticamente al verde porque significa frescura. Entonces, con este nuevo diseño de túneles es posible destacar del resto, porque hoy todos llegan más o menos con la misma calidad de raquis. Ya te quiero ver cuando llegues con un raquis más verde, como si estuviera recién cosechado. Va a tener un impacto en tus resultados comerciales. Cuando hay competencia, el que tiene una mejor oferta de producto va a tener un mejor precio. En Perú no hay ninguno instalado porque vino la pandemia y la inestabilidad por cambio de Gobierno. De lo contrario, estos túneles ya estarían también presentes en Perú. Eso no me cabe ninguna duda.

– En la práctica te has convertido en un ingeniero de refrigeración.
– He podido entender el lenguaje de la industria de la refrigeración. Básicamente, yo les digo lo que quiero, porque generalmente así funciona esto. Lo que ocurre hoy es que la empresa productora de frutas le dice a la empresa de refrigeración que quiere un frigorífico, pero sin mayor descripción de cómo construir la planta que necesita. Entonces, yo lo que hago es ver las necesidades de la empresa exportadora, en base a mis conocimientos. Entonces, les detallo lo que deben pedirle a la empresa de refrigeración. Algunas veces esta responde que nunca ha hecho lo que le piden, que mejor hacerlo como lo hizo en tal empresa. En este caso, toca tener los pantalones o la falda bien puesta -como le quieran llamar-, para pedir que cumplan con lo solicitado. Lo curioso es que al final esto te saldrá más barato que lo tradicional.
EN ENVASES Y EMBALAJES TAMBIÉN SE COMETEN ERRORES
El mito de no enfriar rápido también acompaña a quienes se encargan de los envases y embalajes de la fruta, según comenta el especialista. “El hecho que el 80% de la industria en el mundo crea que tú tienes que enfriar lento hace que los envases y embalajes (cajas, bolsas contenedores, clamshell, etc) trabajen bajo ese fin”, apunta.
– ¿Cuál es el error más común que se comete en esta parte de la postcosecha?
– Usar, por ejemplo, bolsas muy ventiladas. Aquí me gustaría comentar algo. Chile aprendió de California cuando estábamos empezando. Hubo un tremendo convenio entre la Universidad de Chile y la Universidad de California, Davis, financiado por la Fundación Ford. Nosotros tuvimos todos los especialistas de California en Chile. En tanto, Chile se convirtió en un mentor de la industria frutícola peruana. Perú aprendió de los expertos chilenos. ¿Qué ha pasado ahora? Para nosotros, cuando venían los californianos a brindarnos sus conocimientos eran como semidioses. Lo que decían era así. A ustedes les ha venido pasando lo mismo. Últimamente, hay ‘seudoasesores’ chilenos en el tema de postcosecha que realmente no tienen idea de lo que se debe hacer y como les creen, les hacen caso. Entonces, volviendo al tema de la pregunta de los envases. Hay asesores chilenos que están diciendo que en la bolsa contenedora tenemos que tener 1.3% o 2% de área ventilada. Incluso, escuché a otro decir que era necesario tener 3% de área ventilada, cuando es lo contrario. Debemos ir a un 0.3%, 0.2% e, incluso, a un 0% de área ventilada. Están totalmente equivocados. No estoy diciendo que soy el dueño de la verdad, pero soy especialista.
– Entiendo que, entonces, se están alterando principios básicos.
– Lo que pasa es eso, que están rompiendo principios básicos. Y las consecuencias las están pagando los exportadores peruanos. Pero, como dice un amigo españ
ol, todo cae por su propio peso, más temprano que tarde.
– ¿Cuáles son tus próximos proyectos o retos personales en postcosecha?
– Como profesional puedo ser muy estricto y muy duro, pero nunca van a negar que lo primero que quiero es que te vaya bien. Crecí en el campo y sé el sacrificio de ser productor de fruta. Ver que una central frutícola o agroindustrial lo tiene todo para cuidar esa fruta, mantenerla y evitar el deterioro, pero hacen estupideces, créeme, que eso me molesta tremendamente.
– ¿Hay mucho por hacer aún en el manejo postcosecha?
– Nosotros trabajamos con fruta perecedera. Por lo tanto, mientras más tiempo quieras almacenar una especie para un viaje largo, cada vez los detalles van a ser más importantes en la cadena de frío. Entonces, el manejo de la cadena de frío no te lo vas a poder zafar, porque es de lejos la mejor herramienta; obviamente, ayudándote con otras tecnologías, pero siempre será la principal herramienta para poder mantener la calidad y evitar el deterioro de la fruta.
BIO:
Luis es ingeniero agrónomo por la Universidad de Chile y doctor por la Universidad de Maryland (EE UU). Es especialista en postcosecha de frutas, asesor internacional, profesor de la Facultad de Ciencias Agronómicas, Departamento de Producción Agrícola de la Universidad de Chile. Además, es experto en manejo de cadena de frío, almacenamiento y transporte de fruta fresca.